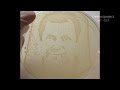

| |
|
 | | time | views | |
 | CNET How To - iOS 8's advanced photo-editing tools | 2:24 | 0 | |
 | The 404 - 1,553: Google location history freak out, $200 Kindle Voyage too much? | 31:12 | 0 | |
 | The Timex Ironman One GPS+ smartwatch lets you leave the phone behind | 2:15 | 0 | |
 | CNET Update - Rounding up Amazon's 7 new Kindles | 2:55 | 0 | |
 | Lenovo brings the flexibility of a Yoga to its touchscreen Chromebook | 2:43 | 0 | |
 | Belkin's WeMo LEDs light up the smart home | 2:15 | 0 | |
 | CNET How To - Disable lock screen app suggestions on iOS 8 | 1:15 | 0 | 1 list |
 | Motorola's Moto X (2014) is a premium, customizable winner | 2:35 | 0 | |
 | CNET How To - Install a custom keyboard on iOS 8 | 1:24 | 0 | 1 list |
 | Kindle Voyage: Amazon's new high-end e-ink reader (hands-on) | 1:57 | 0 | |
 | LG 55EC9300 OLED TV: the best picture quality ever | 2:58 | 0 | |
 | Tomorrow Daily - 053: Incredible multiscreen interaction from MIT's THAW project, and more | 23:44 | 0 | |
 | CNET How To - Make text bigger in iOS 8 | 0:41 | 0 | 1 list |
 | CNET Update - Amazon's new Kindle and Facebook's mini Facebook | 2:53 | 0 | |
 | CNET How To - iOS 8 gives Find My iPhone a boost | 1:30 | 0 | 1 list |
 | CNET How To - Install and manage widgets in iOS 8 | 0:58 | 0 | |
 | Use interactive notifications in iOS 8 | 0:54 | 0 | 1 list |
 | Save battery life in iOS 8 | 0:48 | 0 | 1 list |
 | Ask the Experts: iPhone Overtime | 33:48 | 0 | |
 | Don't bank on Oplink's Connected Video security kit | 1:41 | 0 | |
 | iOS 8 brings tons of small refinements | 2:48 | 0 | |
 | Improving your images in iOS 8 | 1:30 | 0 | |
 | CNET How To - Check out library books on any device | 2:16 | 0 | |
 | Type faster with the iOS 8 keyboard | 0:55 | 0 | |
 | More ways to communicate in iOS 8 | 1:12 | 0 | |
 | The T-Mobile CellSpot is an award-winning Asus router in disguise | 3:34 | 0 | |
 | Apple iPhone 6 vs. 6 Plus camera comparison | 2:00 | 0 | |
 | Apple's iPhone 6 Plus is big, bright, and beautiful | 2:36 | 0 | |
 | Tech Minute - Getting blitzed on football tech | 1:40 | 0 | |
 | CNET News - iPhone 6 vs. iPhone 6 Plus | 1:46 | 0 | |
 | iPhone 6, reviewed and up close | 2:59 | 0 | |
 | iPhone 6 and 6 Plus features, compared | 2:31 | 0 | |
 | A closer look: iPhone 6, 6 Plus design | 1:37 | 0 | |
 | Tomorrow Daily - 052: Cheetah-bot goes off-leash, the coolest 'Star Wars' house ever, and more | 23:24 | 0 | |
 | The 404 - 1,552: Don't bring Surge back, PS4 Nike Air Jordans have HDMI ports | 33:90 | 0 | |
 | Googlicious - The LG G3 brings a Stylus | 4:30 | 0 | |
 | CNET Update - What to expect when upgrading to iOS 8 | 2:52 | 0 | |
 | 5-inch Moto G fits your budget and your hand | 1:54 | 0 | |
 | Canon SX60 HS packs all the zoom you can handle | 1:29 | 0 | |
 | Tomorrow Daily - 051: Microsoft buys Minecraft, a jetpack for running, ant-size radios, and more | 21:20 | 0 | |
 | On the road: 2015 Chrysler 200C | 8:30 | 0 | |
 | Top 5: Things we value most in car infotainment | 2:52 | 0 | |
 | CNET Update - iPhone 6 Plus could be hard to find on launch day | 2:56 | 0 | |
 | CNET On Cars - Car Tech 101: How to get TV in your car | 3:16 | 0 | |
 | Smarter driver: How fast are the drivers in your state? And why it matters | 2:12 | 0 | |
 | Digital Storm Krypton offers the same parts and design as other gaming laptops, for less. | 2:00 | 0 | |
 | Bunn's Velocity brewer makes delicious coffee incredibly fast | 2:33 | 0 | |
 | Canon 7D Mark II brings the speed | 2:00 | 0 | |
 | Canon joins the 1-inch club with the PowerShot G7X | 1:52 | 0 | |
 | Car Tech 101: OBD-II apps and dongles | 3:40 | 0 | |
 | CNET Top 5 - Reasons not to buy an Apple Watch | 3:13 | 0 | |
| Crave - Science and art team up to create cancer cell and bacteria portraits, Ep. 174 | 5:18 | 0 | |
 | CBS Interactive Intern Program 2014 | 3:30 | 0 | |
 | CNET On Cars - 2015 Chrysler 200C: A dud no longer - Ep. 50 | 21:42 | 0 | |
 | The 404 - 1,551: Batman ruined? How to live forever, GTA V new-gen date and details | 33:37 | 0 | |
 | CNET Update - Apple's free album has some folks mad about U2 | 2:56 | 0 | |
 | Take a look at the luxurious, metal Samsung Galaxy Alpha | 2:00 | 0 | |
 | Samsung Galaxy S5 Mini flaunts flagship looks and compact body | 1:41 | 0 | |
 | Dell's Inspiron 14 5000 a good middle-of-the-road thin-and-light that won't break you | 1:53 | 0 | |
 | CNET UK Podcast - Six of the best? iPhone 6 and Apple Watch - Ep. 402 | 43:31 | 0 | 1 list |
 | CNET News - CNET News - T-Mobile CEO accuses rivals of 'trickery' over iPhone deals | 5:23 | 0 | |
 | With one word, T-Mobile CEO John Legere slams his competition | 0:44 | 0 | |
 | CNET News - Could BlackBerry and T-Mobile reconcile? | 1:11 | 0 | |
 | Tech Minute - Tech to help you plan school lunches | 1:60 | 0 | |
 | Tomorrow Daily - 050: Intel's high-tech wheelchair, the new Batmobile, and more | 24:24 | 0 | |
 | Dell Venue 8 7000 makes 3D camera its focus | 2:10 | 0 | |
 | Apple Byte - The iPhone 6 nails it. The Apple Watch...Not so much. | 7:10 | 0 | |
 | The 404 - 1,550: Jill Schlesinger, the NFL's untouchable brand, three financial musts | 52:42 | 0 | |
 | Bose FreeStyle Earbuds: In-ear headphones for people who don't like in-ears | 2:17 | 0 | |
 | Car Tech - 2015 Lexus NX 200t | 4:33 | 0 | |
 | CNET Update - Facebook tests self-destructing posts | 2:56 | 0 | |
 | Tomorrow Daily - 049: New Apple products, a (literal) sandbox game, living portraits, and more | 26:40 | 0 | |
 | The CraveCast - Be a food zombie with the CraveCast crew, it's slimming!, Ep. 5 | 36:14 | 0 | |
 | CNET News - Why Apple Pay may be more exciting than the Apple Watch | 1:41 | 0 | |
 | Chunky Cross Country smartwatch does it all | 1:30 | 0 | |
 | Vizio's sound stand only so-so | 1:23 | 0 | |
 | Coolpad phones, aisle five! | 1:18 | 0 | |
 | The 404 - 1,549: Fall videogame round-up, Apple Watch and Apple Pay, male birth control | 39:53 | 0 | |
 | CNET Update - As iPod Classic meets its end, here come the smartrings | 2:54 | 0 | |
 | Featherlight Lenovo Tab S8 weighs about half a pound | 1:18 | 0 | |
 | CNET's IFA 2014 blooper reel | 2:27 | 0 | |
 | The LaCie D2 Thunderbolt 2 costs a lot of money | 2:32 | 0 | |
 | Tech Minute - Why Tom Hanks' typewriter app clicks | 1:30 | 0 | |
 | Seriously slim: Yezz Billy 4.7 | 1:32 | 0 | |
 | Look out, Note 4. Alcatel's Hero 2 has a stylus, too | 1:40 | 0 | |
 | The 404 - 1,548: Mega iPhone 6, 6 Plus, Apple Pay and Apple Watch wrap-up extravaganza! | 49:25 | 0 | |
 | Looking at Alcatel's Fierce 2, Evolve 2 for T-Mobile | 1:10 | 0 | |
 | Hands-on with Apple's Watch | 2:00 | 0 | |
 | What Apple announced and what matters | 2:19 | 0 | |
 | iPhone 6 and 6 Plus | 2:40 | 0 | |
 | The Fix - Safe and effective ways to use Siri | 4:32 | 0 | |
 | CNET News - U2 debuts new album and makes available for free on iTunes | 1:45 | 0 | |
 | CNET Update - Apple Watch offers new way to communicate, pay | 2:57 | 0 | |
 | CNET News - Apple Watch brings iPhone functionality to your wrist | 5:10 | 0 | |
 | CNET News - Apple turns iPhone 6 into mobile wallet with Apple Pay | 3:14 | 0 | |
 | Apple Watch Sport, hands-on | 0:39 | 0 | |
 | CNET News - Watch what the new iPhone cameras can do | 1:80 | 0 | |
 | Apple September 9 event | 4:09:30 | 0 | 1 list |
 | CNET News - iPhone 6 and 6 Plus boast larger, sharper displays | 4:50 | 0 | |
 | CNET News - Apple boldly enters wearable market with Apple Watch | 3:18 | 0 | |
|
|
|